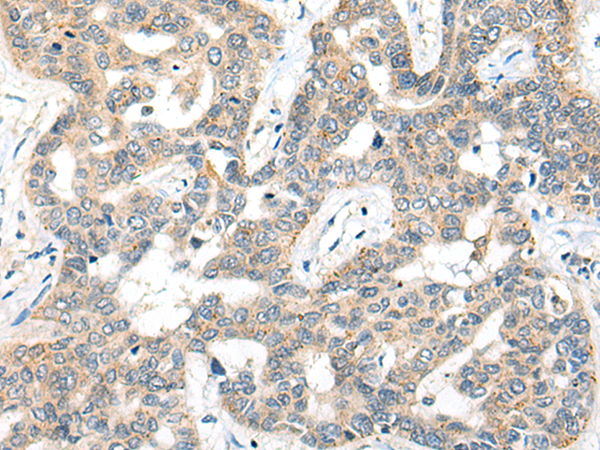

-
分类: 科研抗体货号: P13179别名: NL1应用: IHC反应种属: Human, Mouse, Rat
-
分类: 科研抗体货号: P13162别名: MNB; DYRK; HP86; MNBH; MRD7; DYRK1应用: WB,IHC反应种属: Human, Mouse, Rat
-
分类: 科研抗体货号: P13196别名: SISd; eoCP; SCYA5; RANTES; TCP228; D17S136E; SIS-delta应用: IHC反应种属: Human, Mouse, Rat
-
分类: 科研抗体货号: P13178别名: IIP45应用: IHC反应种属: Human
-
分类: 科研抗体货号: P13161别名: MRGX; MORFL2应用: WB,IHC反应种属: Human, Mouse, Rat
-
分类: 科研抗体货号: P13195别名: MCH4; ALPS2; FLICE2应用: IHC反应种属: Human
-
分类: 科研抗体货号: P13177别名: KP78; CTAK1; PAR1A; Par-1a应用: WB,IHC反应种属: Human, Mouse, Rat
-
分类: 科研抗体货号: P13160别名: PRP8; RP13; HPRP8; PRPC8; SNRNP220应用: WB,IHC反应种属: Human, Mouse
-
分类: 科研抗体货号: P13176别名: EMK1; EMK-1; PAR-1; Par1b; Par-1b应用: WB,IHC反应种属: Human, Mouse, Rat
-
分类: 科研抗体货号: P13190别名: TFAF2; MSTP010应用: IHC反应种属: Human, Mouse

鄂公网安备42018502007531号
鄂公网安备42018502007531号

